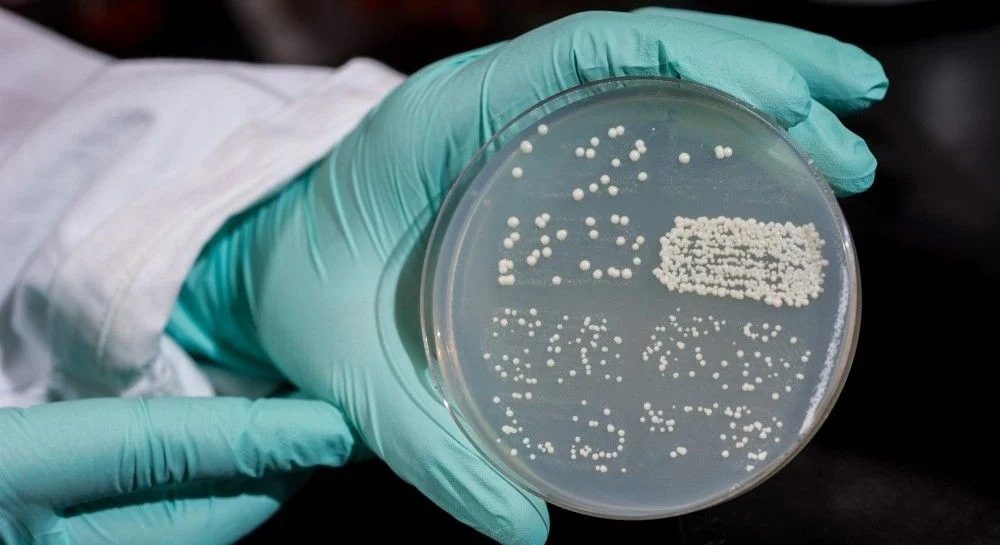

Кількість випадків Candida auris подвоїлась за останні 20 років у США, повідомив Центр з контролю та профілактики захворювань (CDC, США). Кількість випадків зросла на 44% до 476 у 2019 році з 330 у 2018 році, а потім на 59% до 756 у 2020 році та ще на 95% до 1471 у 2021 році, повідомили дослідники агентства. У звіті не було даних за 2022 рік, але на офіційних джерелах CDC зазначено 2377 випадків підтверджених інфекцій Candida auris у США. Минулого року відбулося різке зростання порівняно з 53 у 2016 році, коли вперше було зареєстровано випадки в країні. Занепокоєння викликає також зростання кількості резистентних до лікування випадків.

Найпоширеніші симптоми Candida auris включають високу температуру та озноб, які не зменшуються після лікування антибіотиками при підозрі на бактеріальну інфекцію, згідно з рекомендаціями CDC . Якщо інфекція поширюється, можуть розвинутися додаткові симптоми.
Доктор Уолід Джавайд, епідеміолог, експерт з інфекційних хвороб і директор відділу профілактики та контролю інфекцій у центрі міста Маунт-Сінай у Нью-Йорку, сказав, що нові відкриття викликають «тривогу». Але вони не означають, що світу загрожує апокаліпсис, зображений в популярному теле-серіалі.
Швидке зростання та географічне поширення випадків викликає занепокоєння та підкреслює необхідність постійного нагляду, розширення потужностей лабораторії, швидших діагностичних тестів та дотримання перевірених заходів профілактики та контролю інфекцій
У CDC зазначають, що поширення інфекції могло статись через стрес, який відчувала система охорони здоров’я через пандемію коронавірусної інфекції, зокрема нестачу обладнання та персоналу. Також, на думку експертів кількість нових випадків могла зрости через настороженність медичного персоналу і посилений скринінг. Випадки не обмежуються густонаселеними столичними районами, зараз захворювання реєструють в половині штатів, в основному йдеться про місцеву передачу.
За словами дослідників, інші країни також повідомили про збільшення поширення грибка.
За матеріалами: CDC NewsRoom
0